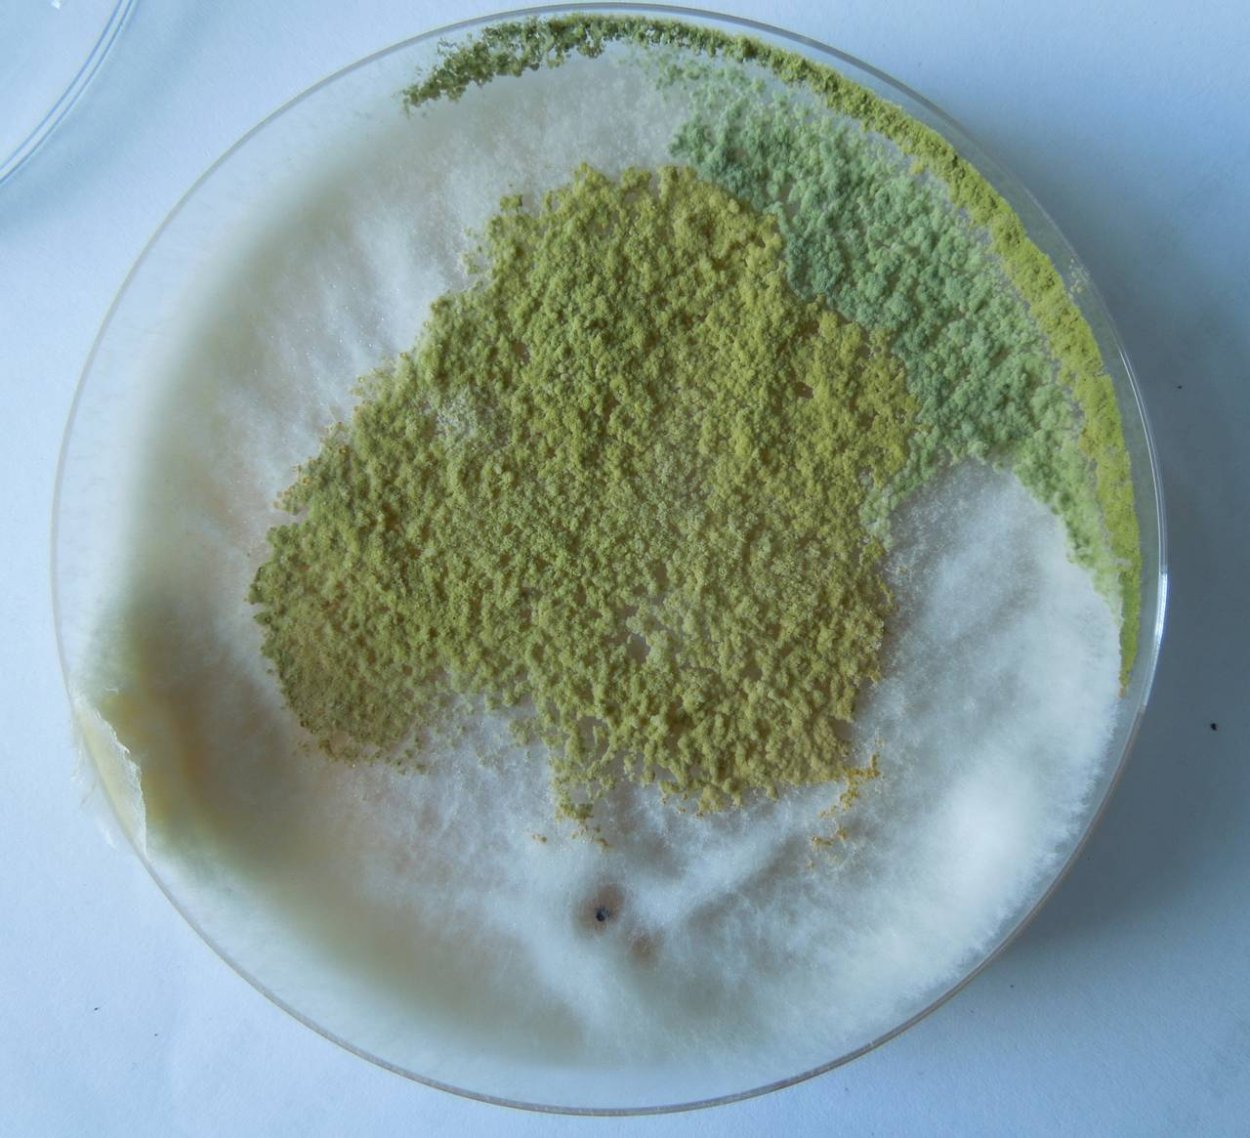
Триходерма viride
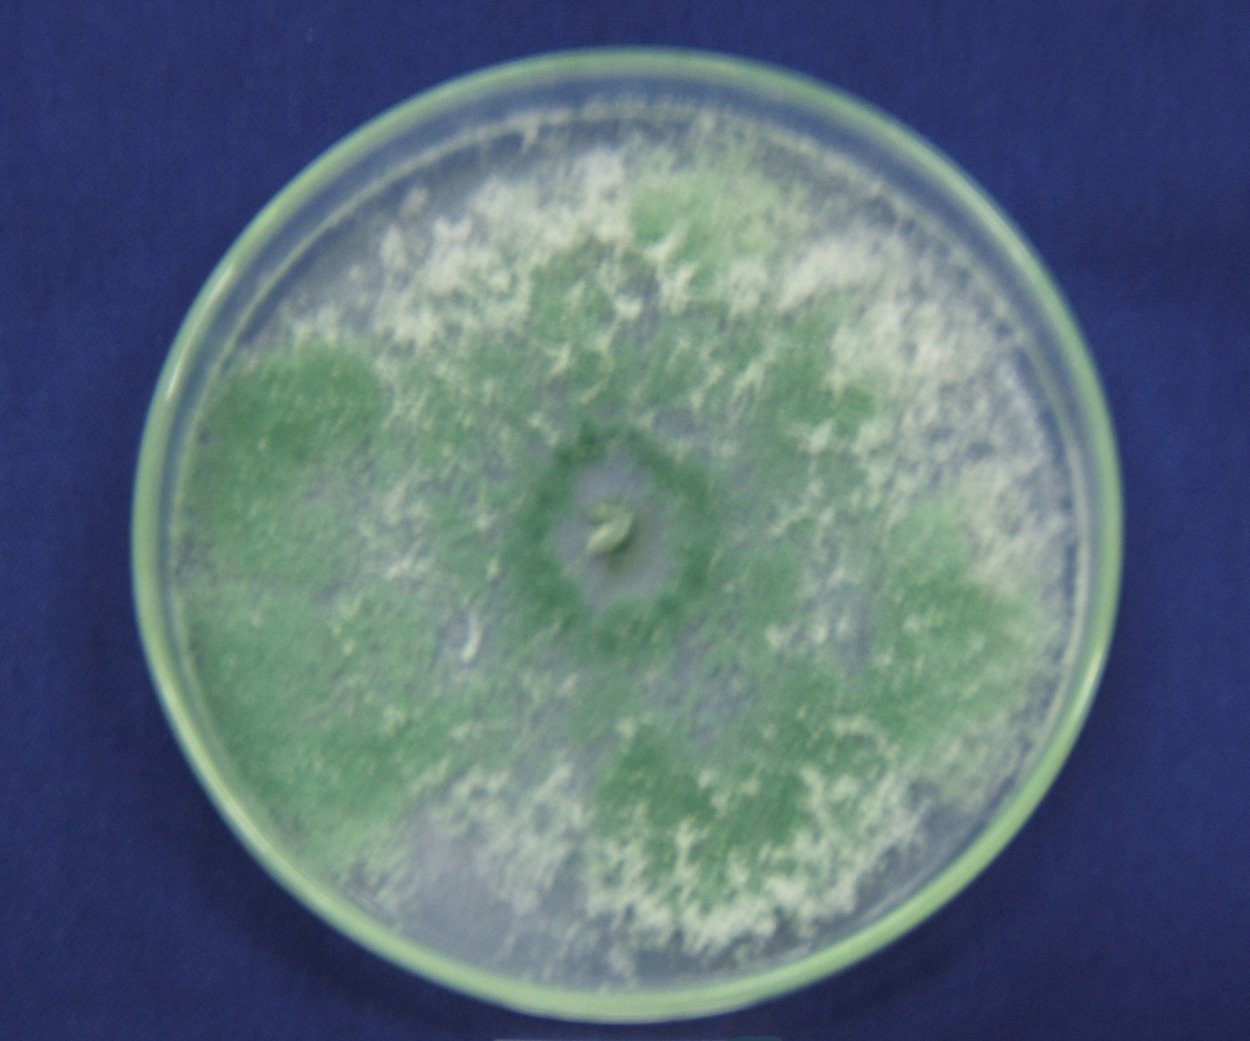
Триходерма harzianum
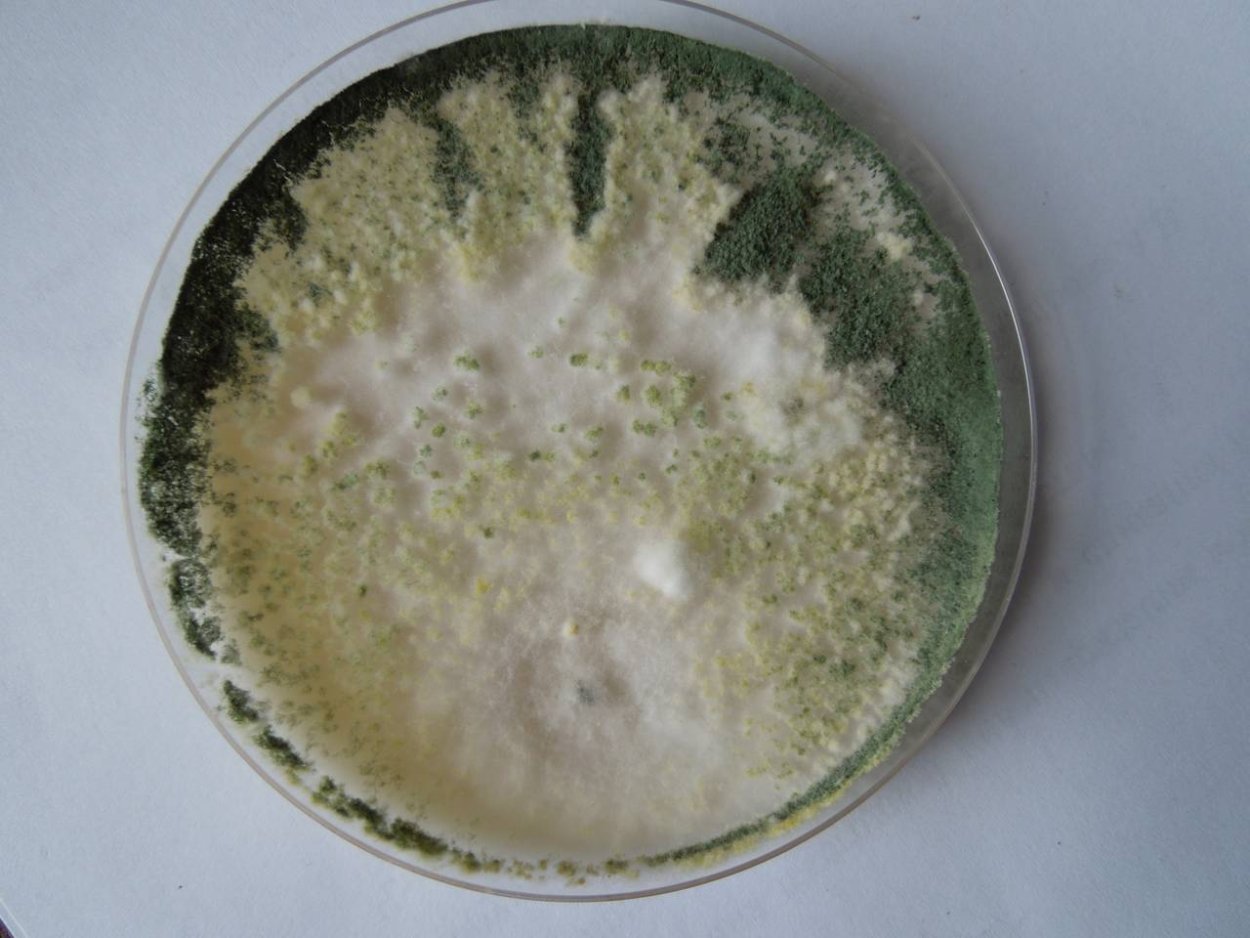
Trichoderma viride триходермина
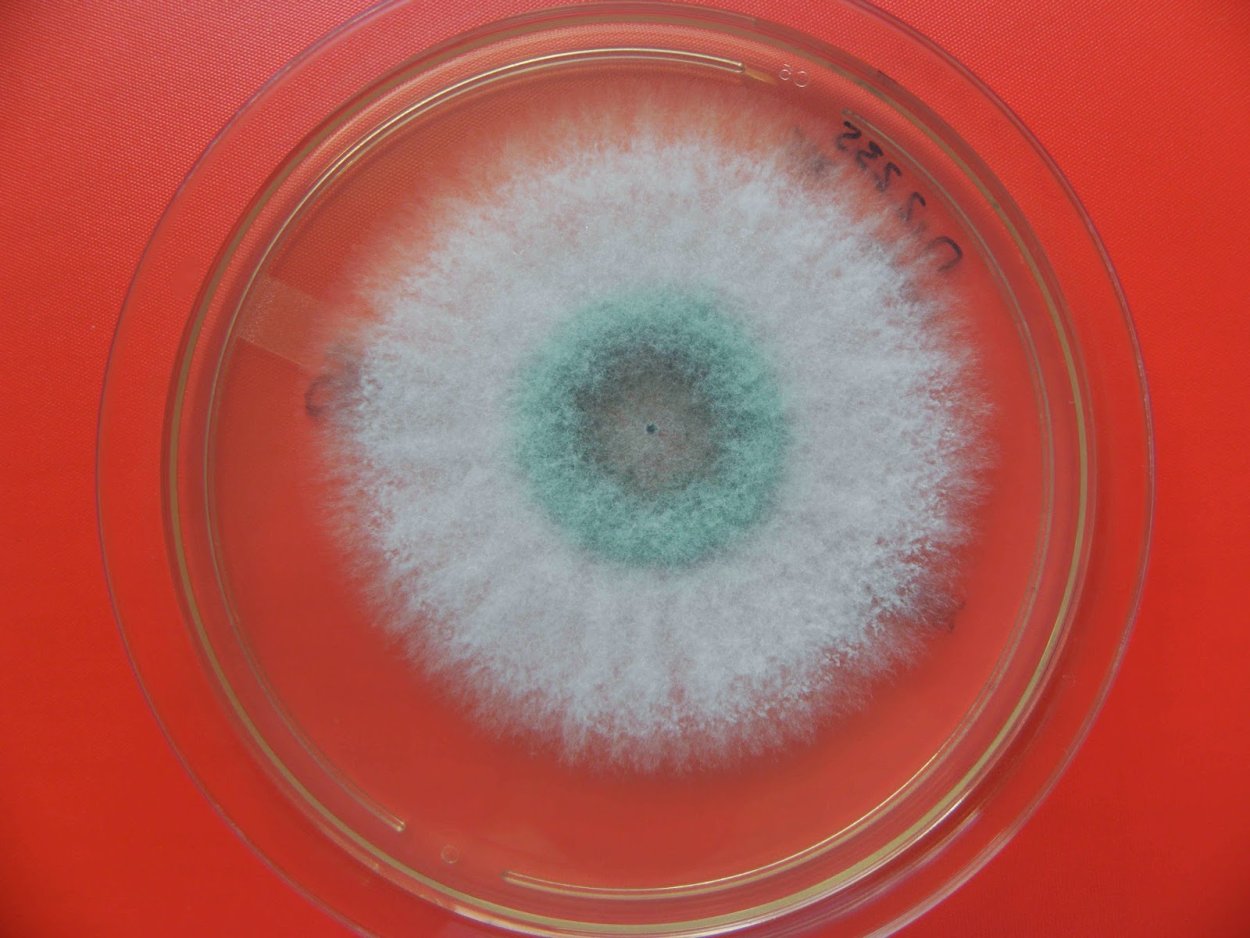
Триходерма пульвинатум
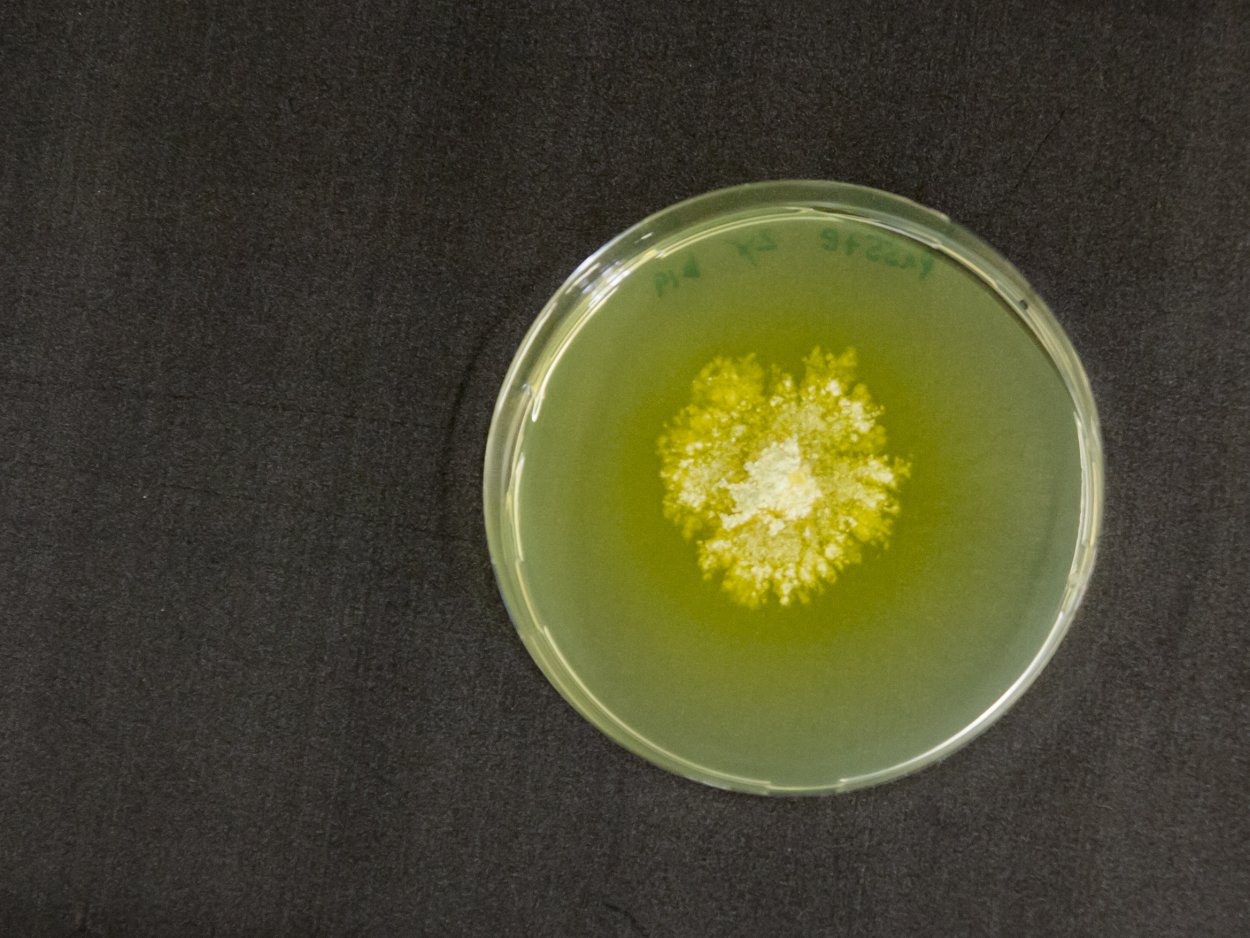
Триходерма желтая
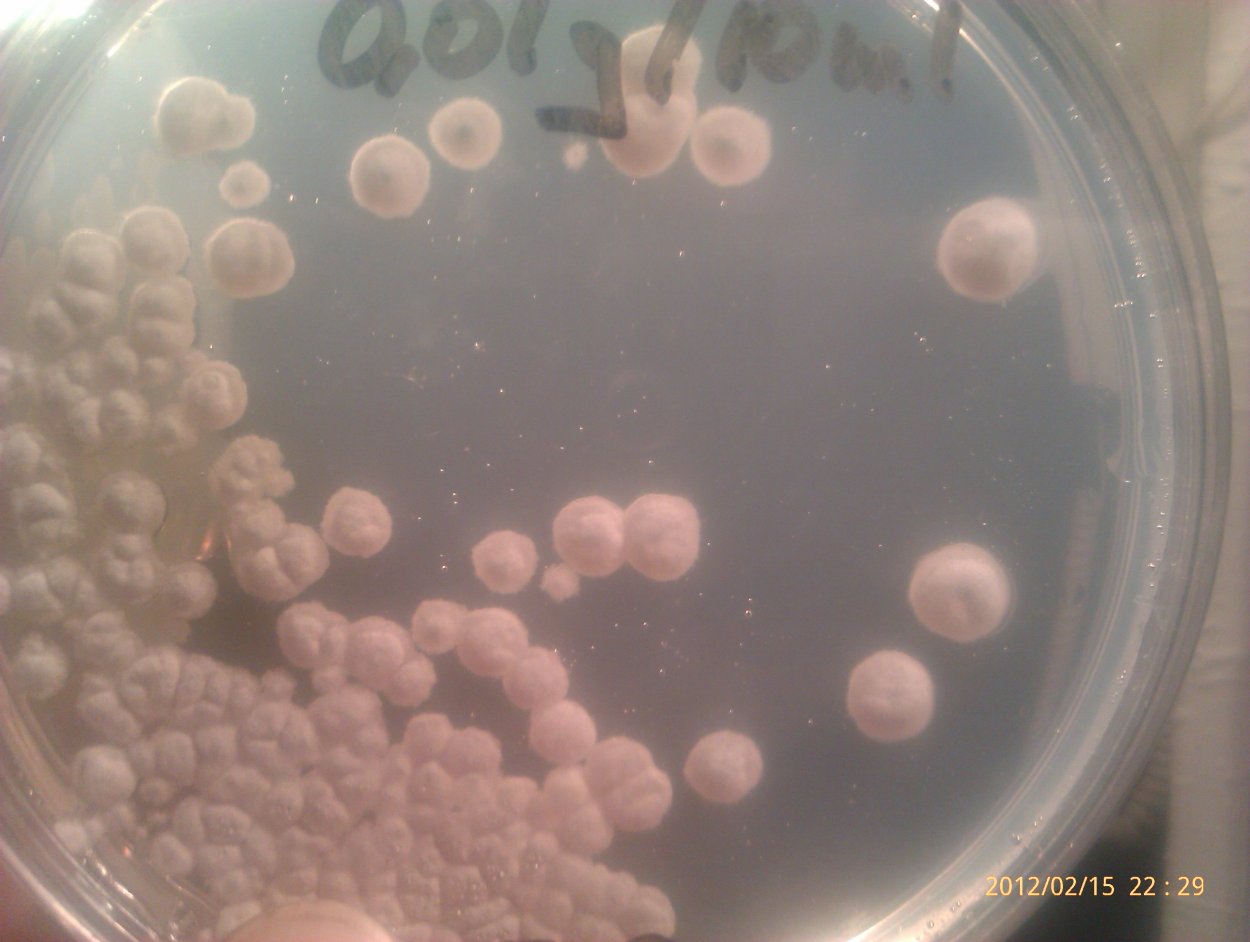
Trichoderma atroviride
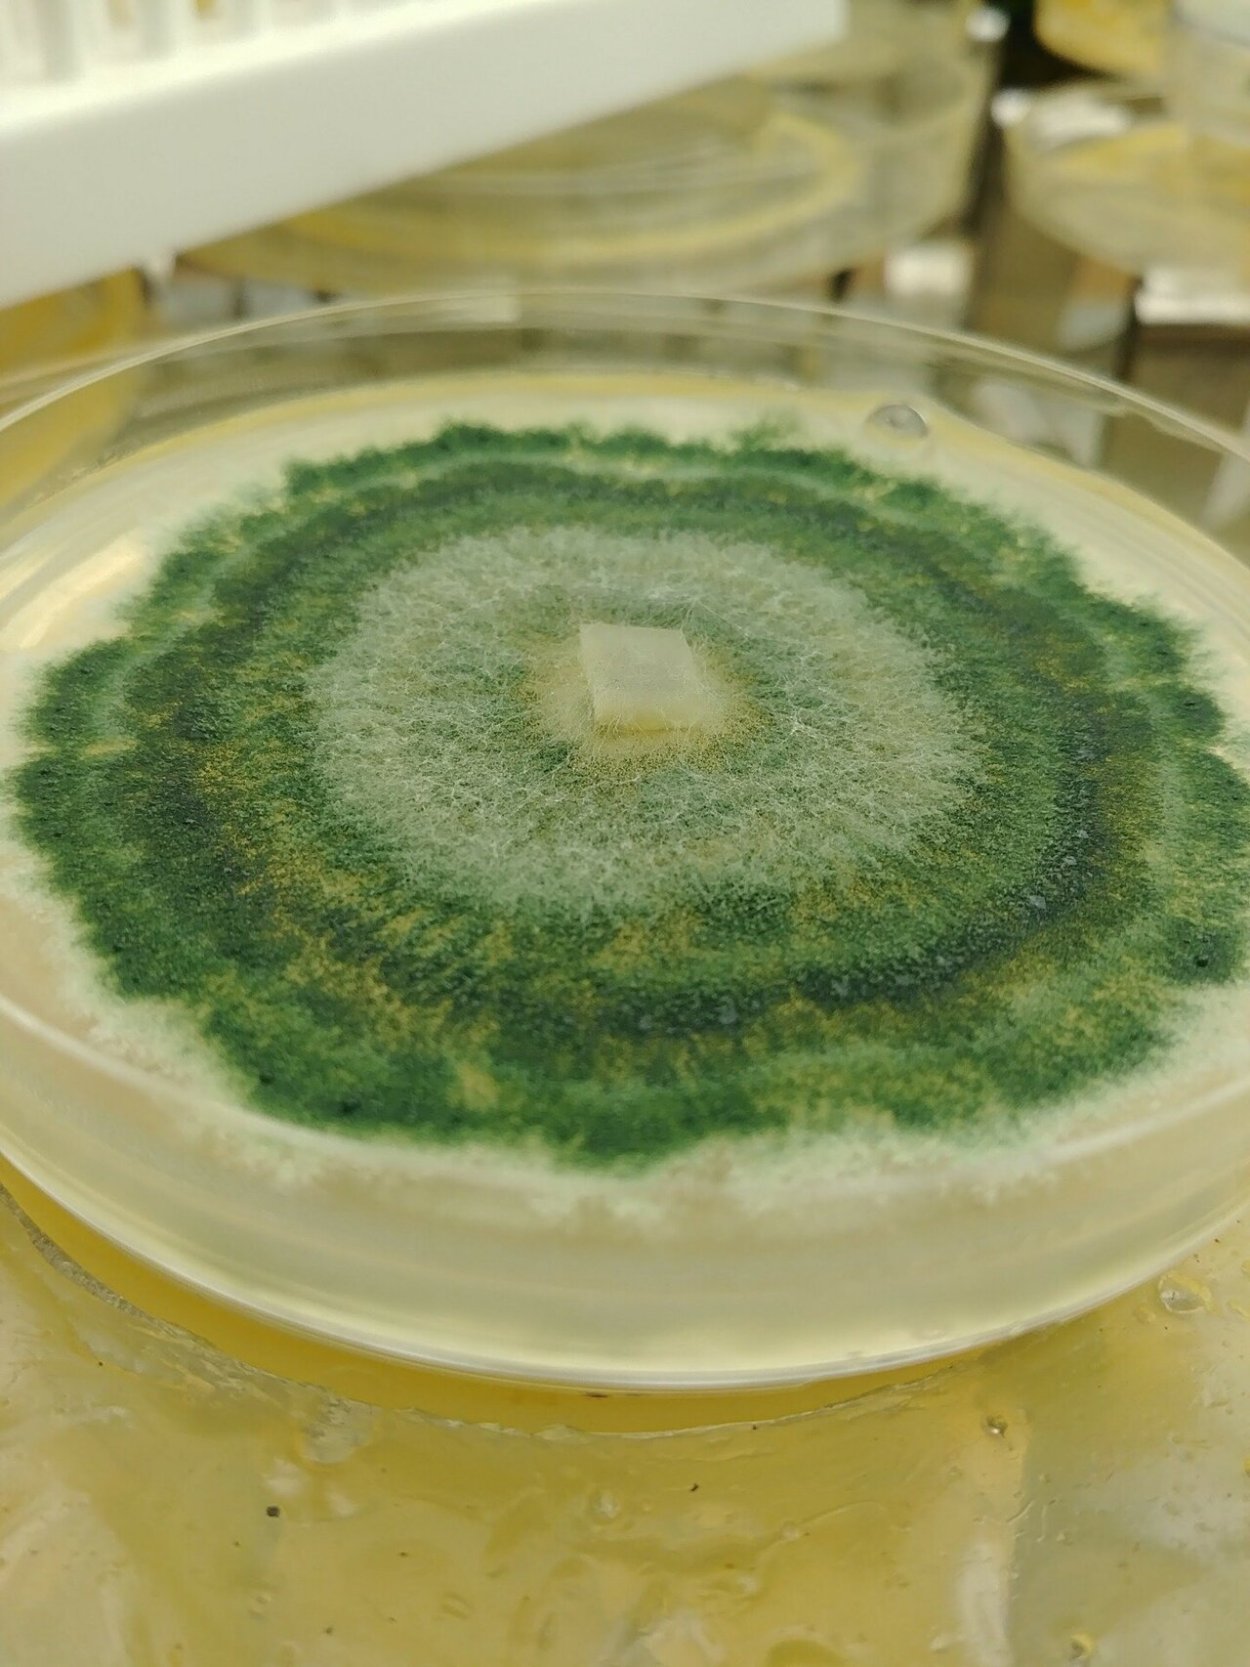
Триходерма Глиокладин чашке Петри
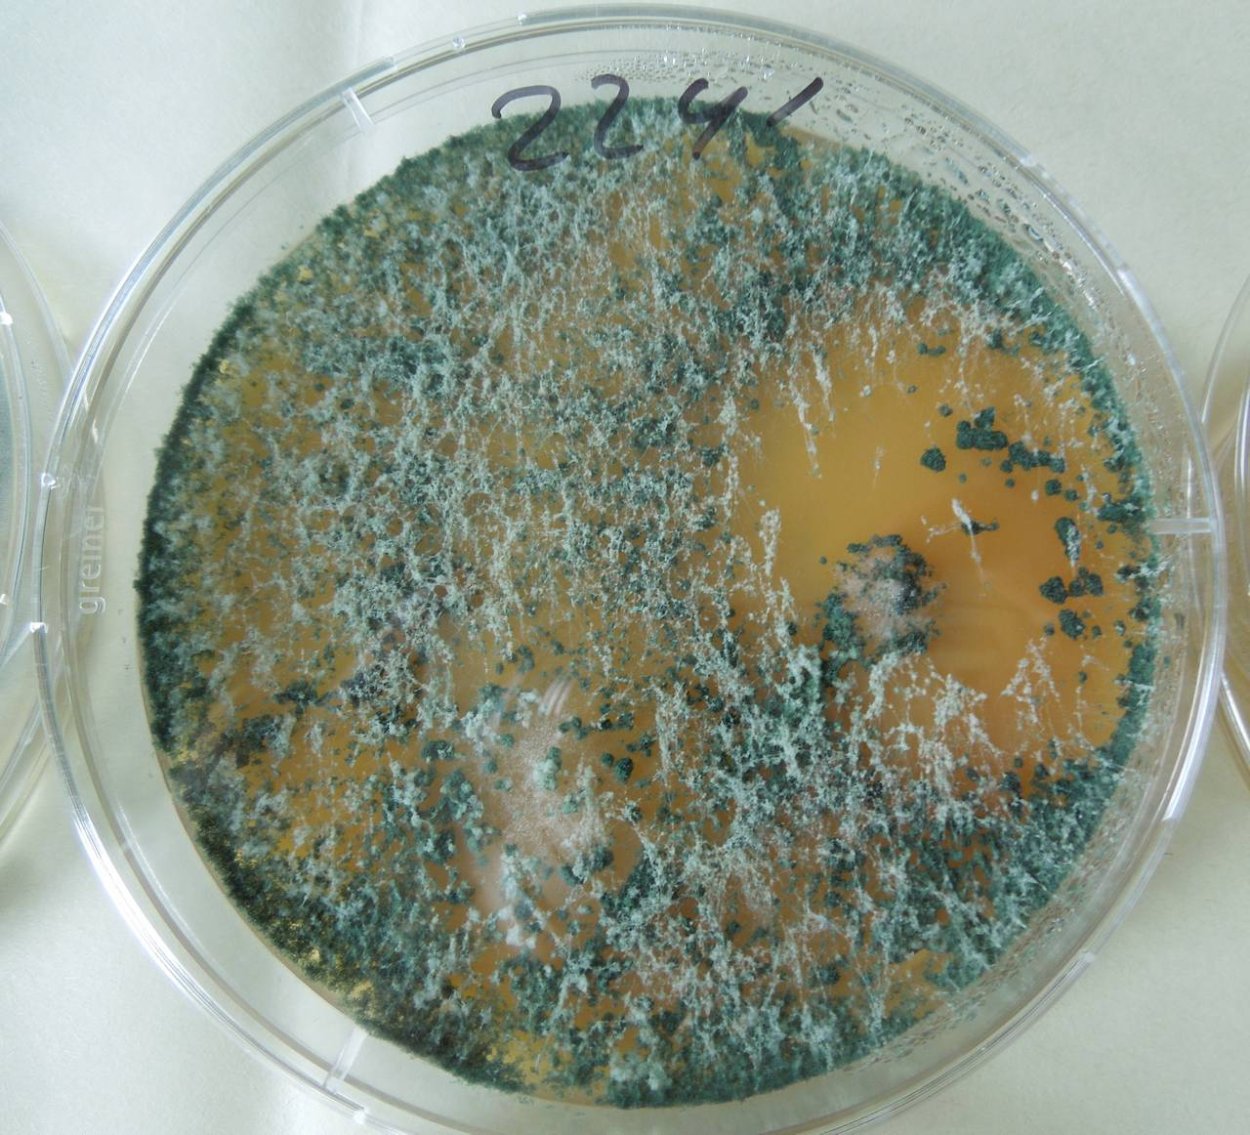
Триходерма Конинга
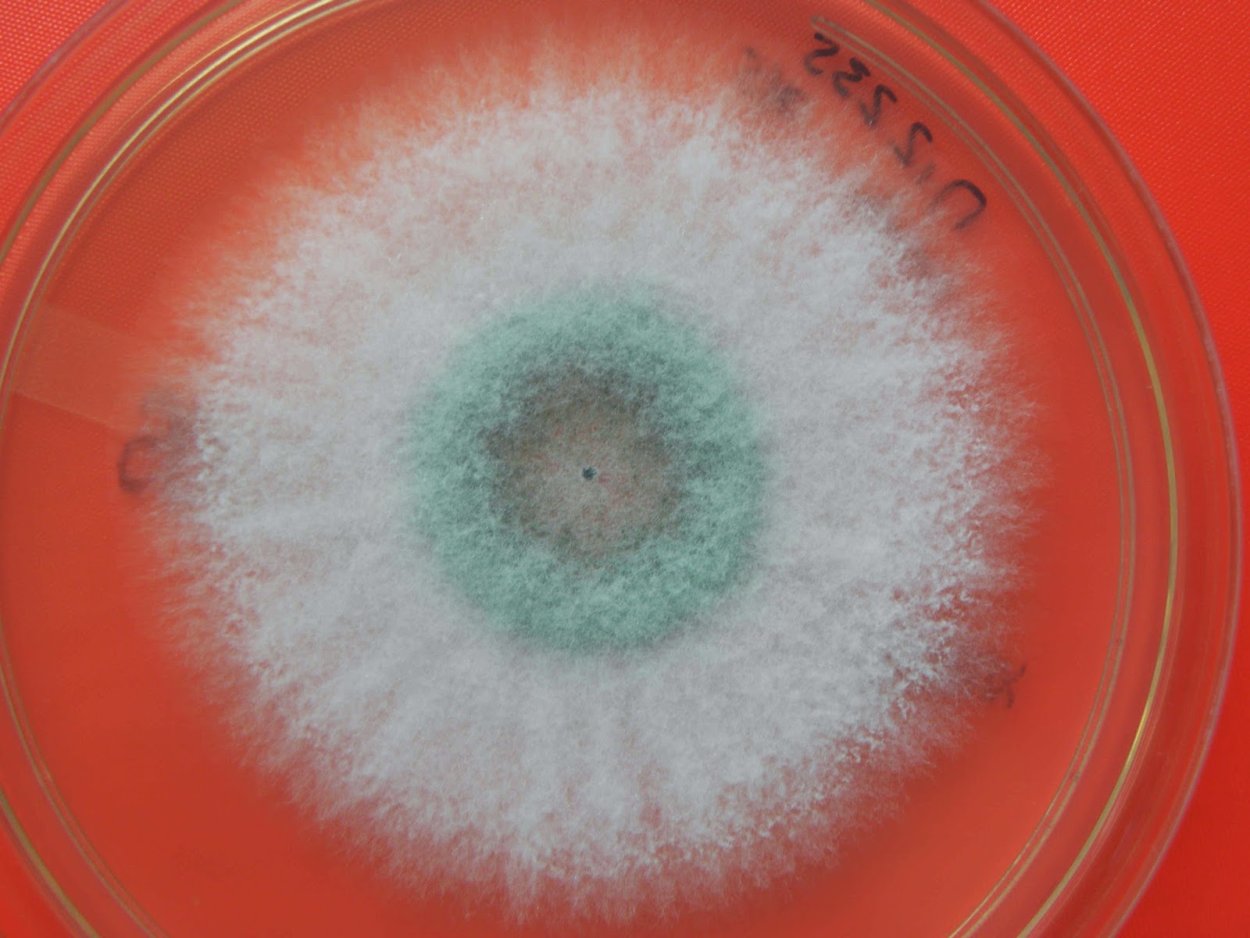
Триходерма лигнорум
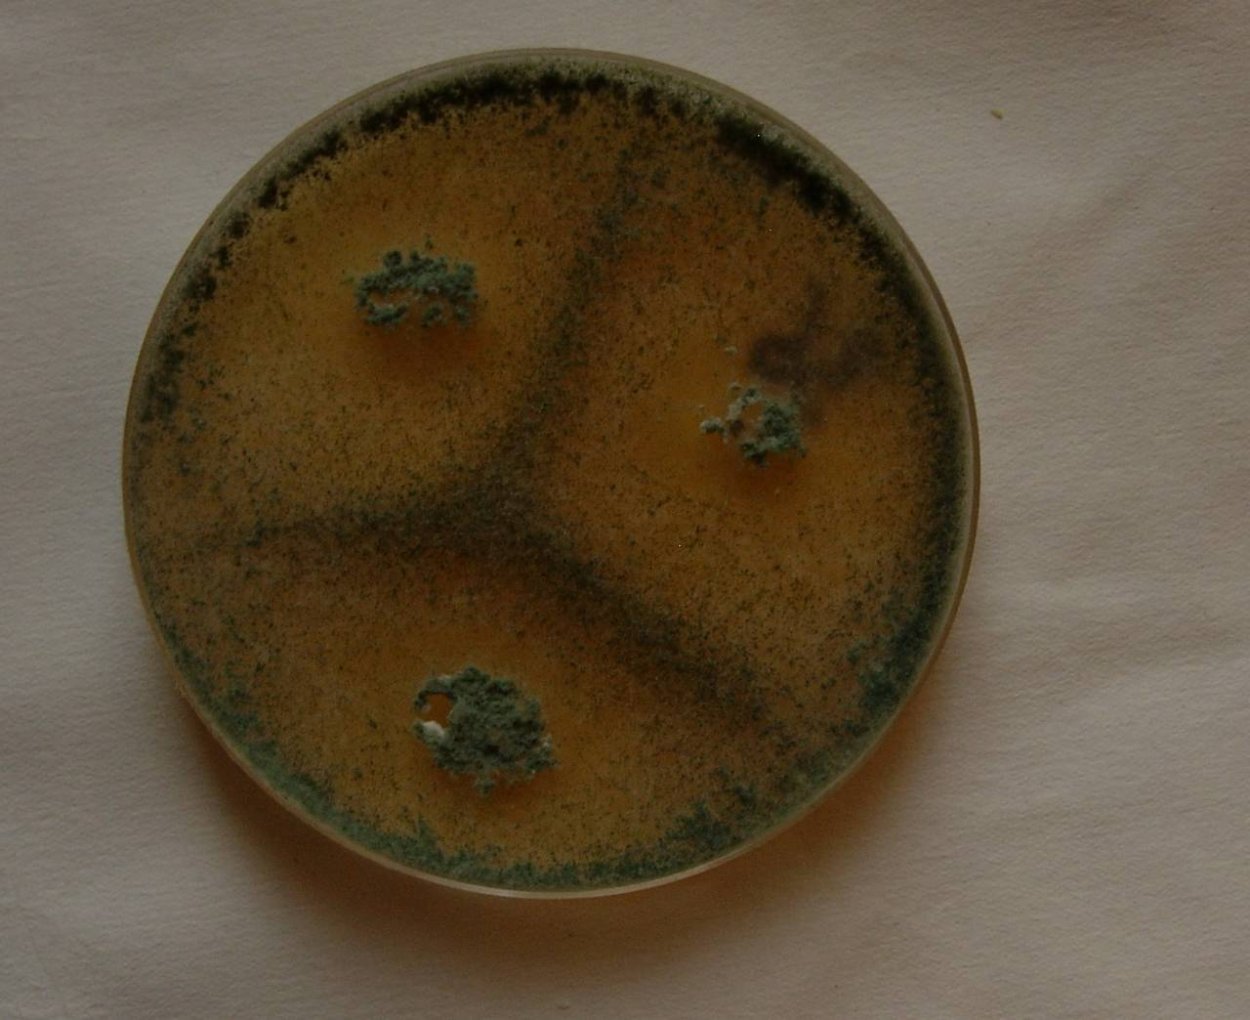
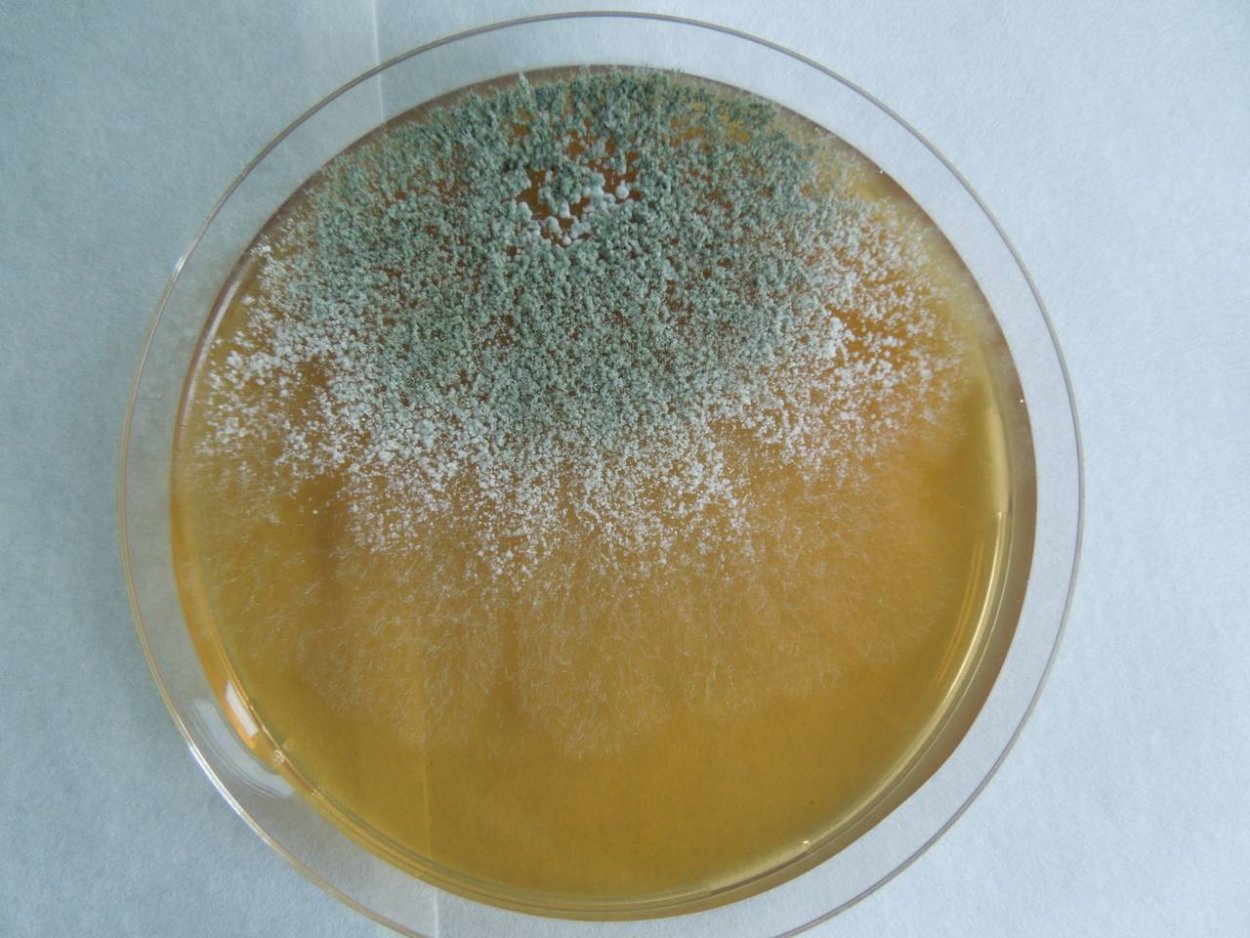
Триходерма лигнорум

Триходерма лигнорум

Гриб триходерма



Триходерма Конинга

Насекомое триходерма

Trichoderma atroviride

Триходерма viride

Споры триходермы

Гриб триходерма

Триходерма Верде

Гриб триходерма виридис

Гипокрея на древесине

Триходерма вериде 15г

Триходерма Конинга

Триходерма лигнорум


Древесные грибы триходерма

Триходерма серая

Гриб триходерма виридис

Trichoderma harzianum мицелий
Триходерма viride

Триходерма Верде мицелий

Триходерма мицелий
Триходерма harzianum

Триходерма зеленая

Триходерма harzianum
Trichoderma viride триходермина

Триходерма зеленая

Stachybotrys alternans

Триходерму харцианум

Trichoderma viride в микроскопе

Триходерма viride

Удобрение триходерма Верде
Триходерма пульвинатум

Триходерма вериде на зерне

Биостимулятор роста растений agrinos

Триходермин 250мл

Кожеед рода триходерма

Грибов рода Trichoderma

Среда для жидкого мицелия

Триходерма viride

Триходерма микроскоп

Триходерма мицелий

Триходерма штаммы

Trichoderma микориза
Триходерма желтая

Грибов рода Trichoderma

Гриб триходерма вериде
Trichoderma atroviride
Триходерма Глиокладин чашке Петри

Биологические препараты

Trichoderma viride в микроскопе

Триходерма штаммы

Триходерма мицелий

Aspergillus и Penicillium

МИКОРАД Триходермин

Гуминовые препараты из торфа

Триходерма в жидкой среде

Trichoderma viride под микроскопом

Trichoderma reesei микроскопирование

Trichoderma harzianum спороношение

Триходерма хорцеанум

Фунгицид триходерма

Триходерма зеленая Trichoderma viride

Гриб Trichoderma reesei

Trichoderma viride строение

Биофунгицид садовый спасатель

Trichoderma viride в микроскопе

Мицелий триходермы под микроскопом
Триходерма Конинга

Триходерма лигнорум
Триходерма лигнорум

Насекомое триходерма

Триходерма Конинга

Гипокрея гриб

Триходермин тн82

Штамм триходерма лигнорум

Триходерма лигнорум

Триходерма лигнорум

Триходерма агробиолаб

Красивая флора